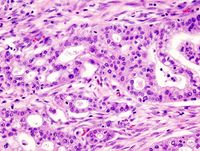

2016 في العلوم
| قائمة الأعوام في العلوم |
|---|
| ... 2006 . 2007 . 2008 . 2009 . 2010 . 2011 . 2012 ... 2013 2014 2015 -2016- 2017 2018 2019 ... 2020 . 2021 . 2022 . 2023 . 2024 . 2025 . 2026 ... |
| الفن . الآثار . العمارة . الأدب . الموسيقى . الفلسفة . العلوم +... |
عدد من الأحداث العلمية الهامة وقعت، أو يُتوقع حدوثها، في 2016. وقد أعلنت الأمم المتحدة 2016 السنة الدولية للبقوليات.[1]
الأحداث
يناير
- 1 يناير
- الباحثون في HRL Laboratories في ماليبو، كاليفورنيا، develop an entirely new way to 3D print near-flawless ceramics, including fantastically heat-resistant varieties that were previously impossible.[2]
- An article published in Science describes how human-machine superintelligence could solve the world's most dire problems.[3]
- 7 يناير
- Scientists report that, about 800 million years ago, a minor genetic change in a single molecule, called GK-PID, may have allowed organisms to go from a single cell organism to one of many cells.[5][6]
- The discovery of the earliest known physical evidence of tea from the mausoleum of Emperor Jing of Han in Xi'an is reported, indicating that tea from the genus Camellia was drunk by Han Dynasty emperors as early as 2nd century BC.[7]
- Astronomers identify IDCS 1426 as the most distant massive galaxy cluster yet discovered, at 10 billion light years from Earth.[4]
- Mathematicians, as part of the Great Internet Mersenne Prime Search, report the discovery of a new prime number: "274,207,281 − 1".[8][9]
- 11 يناير – Glycerol 3-phosphate phosphatase (G3PP), an enzyme that prevents sugar being stored as fat, is identified by scientists at the University of Montreal Hospital Research Centre.[10]
- 13 يناير
- Man-made carbon emissions have delayed the next ice age by 50,000 years, according to researchers at the Potsdam Institute for Climate Impact Research.[11]
- Water ice is confirmed on the surface of comet 67P.[12]
- The world's first 13 TB solid state drive (SSD) is announced, doubling the previous record for a commercially available SSD.[13]
- 14 يناير – Astronomers report that ASASSN-15lh, first observed in June 2015, is likely the brightest supernova ever detected. Twice as luminous as the previous record holder, at peak detonation it was as bright as 570 billion Suns.[14][15]
- 17 يناير – The Jason-3 Earth observation satellite is launched.[16]

20 January: 2015 – Warmest Global Year on Record (since 1880) – Colors indicate temperature anomalies (NASA/NOAA; 20 January 2016).[17]
- 18 يناير
- Man-made heat entering the oceans has doubled since 1997, according to a study in the journal Nature Climate Change.[18][19]
- Light-activated nanoparticles able to kill over 90% of antibiotic-resistant bacteria are demonstrated at the University of Colorado Boulder.[20]
- Researchers demonstrate a new class of small, thin electronic sensors that monitor temperature and pressure within the skull – crucial health parameters after a brain injury or surgery – then melt away when no longer needed. This eliminates the need for additional surgery to remove the monitors and reduces the risk of infection and hemorrhage.[21]
- 19 يناير
- A successful head transplant on a monkey by scientists in China is reported.[22]
- DARPA announces a new program, Neural Engineering System Design (NESD), which aims to greatly improve the bandwidth and quality of neural interfaces, connecting up to a million neurons at a time.[23]
- 20 يناير
- الفلكيون في معهد كاليفورنيا للتكنولوجيا present the strongest evidence yet that a ninth planet is present in the Solar System, orbiting the Sun every 15,000 years.[24][25]
- NASA and the National Oceanic and Atmospheric Administration (NOAA) confirm that 2015 was the hottest year (since 1880) on record globally, shattering the previous record by the largest margin ever seen.[17][26][27]
- 23 يناير – لوكهيد مارتن announces the "Segmented Planar Imaging Detector for Electro-optical Reconnaissance" (SPIDER), a new way of dramatically shrinking the size of telescopes, by using hundreds to thousands of tiny lenses. The diameter does not change, but the SPIDER system is thinner and does not need multiple mirrors.[28]

28 January: Studies suggest that a time reversal asymmetry may make the universe move forward in time.[29]
- 25 يناير
- Researchers at the University of Washington announce a new handheld, pen-sized microscope that could identify cancer cells in doctor’s offices and operating rooms.[30]
- Researchers at the University of Iowa use real-time 3D videos of cellular movement to show how cancer cells extend "cables" and grab other cells, leading to tumour growth. As little as five percent of cancerous cells are needed for tumour formation, they suggest.[31]
- The first ever global nitrogen footprint, encompassing 188 countries, is released by the University of Sydney.[32]
- جامعة نيو ساوث ويلز announces that it will begin human trials of the Phoenix99, a fully implantable bionic eye.[33]
- 27 يناير – Google announces a breakthrough in artificial intelligence with a program able to beat the European champion of the board game Go.[34][35][36]
- 28 يناير
- Research into the nature of time by Griffith University's Centre for Quantum Dynamics shows how an asymmetry for time reversal might be responsible for making the universe move forward in time.[29]
- Observations by the Space Telescope Science Institute in Baltimore, Maryland, suggest that Smith's Cloud did not originate from intergalactic space, but was actually launched out of our own galaxy around 70 million years ago.[37]
- 29 يناير
- Researchers demonstrate that graphene can be successfully interfaced with neurons, while maintaining the integrity of these vital nerve cells. It is believed this could lead to much improved brain implants for restoring sensory functions.[38]
- Proton beam therapy for cancer is as effective as other treatments and causes fewer side effects in children than conventional radiotherapy, according to research published by The Lancet.[39][40]
- Research by UCLA provides further evidence that the Moon was formed by a violent, head-on collision between the early Earth and a “planetary embryo” called Theia, roughly 100 million years after the Earth formed.[41]
فبراير
- 1 فبراير – Scientists in the United Kingdom are given the go-ahead by regulators to genetically modify human embryos by using CRISPR-Cas9 and related techniques.[42][43]
- 2 فبراير – The smallest ever lattice structure is created by the Karlsruher Institut für Technologie (KIT), with glassy carbon struts and braces less than 200 nm in diameter.[44]
- 3 فبراير – Following a helium plasma test in December 2015, the first hydrogen test is successfully conducted at the Wendelstein 7-X fusion device in Germany.[45][46]

11 February: Collision and merger of two black holes, resulting in the first direct observation of gravitational waves.[47][48][49][50]
- 4 فبراير – The National Snow and Ice Data Center reports that the Arctic sea ice extent for January 2016 was the lowest in the satellite record.[51]
- 9 فبراير – A breakthrough in cryopreservation is announced, with a rabbit's whole brain shown to have a well-preserved ultrastructure, including cell membranes, synapses, and intracellular structures such as synaptic vesicles.[52][53]
- 11 فبراير – Scientists at the LIGO, Virgo and GEO600 announce the first direct detection of a gravitational wave predicted by the general relativity theory of Albert Einstein.[47][48][49][54][50]
- 12 February – Scientists publish a list of the world's 2,500 rarest minerals in the journal American Mineralogist.[55][56]
- 15 فبراير
- The University of Southampton announces a major step forward in creating "5D" data storage that can survive for billions of years.[57]
- Scientists report "unprecedented" success using T-cells to treat cancer. In one trial, 94 percent of patients with acute lymphoblastic leukaemia saw their symptoms disappear entirely.[58]
- 16 فبراير
- NASA's Hubble Space Telescope detects hydrogen and helium (and suggestions of hydrogen cyanide), but no water vapor, in the atmosphere of 55 Cancri e, the first time the atmosphere of a super-earth exoplanet has been analyzed successfully.[59]
- A study in Cryobiology describes how microscopic tardigrades were successfully revived, and reproduced, after being frozen for over 30 years.[60][61]
- 17 فبراير – Launch of Hitomi, also known as Astro-H, a spacecraft to study high-energetic processes and dark matter in the universe.
- 19 فبراير – Researchers report that naked mole rats, thought immune to cancer, can contract the disease after all.[62]
- 23 فبراير – Boston Dynamics reveals the latest version of its "Atlas" humanoid robot, featuring highly dynamic movements and reactions in both indoor and outdoor environments.[64]
- 24 فبراير – Pancreatic cancer is found to have four separate sub-types, each with a different cause and requiring a different treatment.[63][65]
- 26 فبراير – A solar cell so thin, flexible, and lightweight that it can be draped on a soap bubble is demonstrated by the Massachusetts Institute of Technology.[66]
مارس
- 2 مارس – Climate change could kill more than 500,000 people a year globally by 2050 by making their diets less healthy, according to research published in the Lancet.[67][68]
- 3 مارس
- The most remote galaxy ever detected – GN-z11 – is confirmed by the Hubble Space Telescope at a distance of 13.4 billion light years.[69]
- The global average temperature briefly spikes 2 degrees C above the pre-industrial average, considered by most countries to be the "dangerous" limit for climate change.[70][71]
- 4 مارس – علماء جامعة كمبردج demonstrate that 'naïve' pluripotent stem cells can be derived from a human embryo. One of the most flexible types of stem cell, these can develop into all human tissue other than the placenta.[72]
- 7 مارس – German researchers identify a specific gene mutation in humans that provides a 50 percent lower risk of suffering a heart attack.[73]
- 9 مارس
- NASA announces that the robotic Mars InSight lander, equipped with a seismometer and a heat transfer probe, has been approved for a 5 May 2018 launch date. The original launch date in March 2016 was cancelled in December 2015 due to a technical failure.[74][75]
- Google's DeepMind AlphaGo artificial intelligence defeats South Korea's Lee Se-dol in the first of a series of Go games in Seoul.[76]
- A total solar eclipse occurred.

14 March: ExoMars Trace Gas Orbiter is launched.[77]
- 10 مارس – Data from Mauna Loa Observatory in Hawaii shows that carbon emissions in 2015 grew at their fastest rate on record.[78]
- 11 مارس – Ideonella sakaiensis, the first species of bacteria able to degrade polyethylene terephthalate, (PET) is described by Japanese researchers.[79][80]
- 14 March – ExoMars Trace Gas Orbiter is launched from Baikonur in Kazakhstan at 09:31 GMT.[77]
- 15 مارس – Fairy circle (arid grass formation) patterns in spinifex are discovered in remote Western Australia; their first discovery outside of Namibia.
- 17 مارس
- Paleontologists report the discovery of a pregnant Tyrannosaurus rex, shedding light on the evolution of egg-laying as well as gender differences in the dinosaur.[81]
- Researchers at Rutgers and Stanford universities develop a novel way to inject healthy human nerve cells into mouse brains, with potential for treating Parkinson's disease and other brain-related conditions, though human trials are likely 10–20 years away.[82]
- Studies suggest that modern humans bred with hominins, including Denisovans and Neanderthals, on multiple occasions.[83]
- Researchers at the University of Toronto use stem cell therapy to reverse age-related osteoporosis in mice.[84]
- 21 مارس – Man-made carbon emissions lead to total carbon emissions 10 times higher than at any point since the extinction of the dinosaurs, according to new calculations by researchers.[85]
- 24 مارس
- Scientists at Florida Atlantic University identify translin as a gene responsible for sleep deprivation and metabolic disorders.[86]
- The cavefish Cryptotora thamicola, able to walk and climb waterfalls, is reported to show anatomical features previously known only in four-limbed vertebrates. Researchers call the finding "huge" in evolutionary terms.[87]
 21 March: Total carbon emissions due to humans 10 times greater than at any time since the extinction of the dinosaurs.[85]
21 March: Total carbon emissions due to humans 10 times greater than at any time since the extinction of the dinosaurs.[85] - Craig Venter's team announce they have synthesised a minimal bacterial genome, containing only the genes necessary for life, and consisting of just 473 genes. This builds upon their earlier research that synthesised Mycoplasma laboratorium in 2010.[88][89]
- 29 March – Case Western Reserve University announces an optical sensor a million times more sensitive than the current best available, with potential for improving early cancer detection.[90]
- 30 مارس
- A study by climate scientists concludes that sea level increases by 2100 could be twice as high as the IPCC's most recent estimates.[91]
- Scientists report that Homo floresiensis, an extinct hominin nicknamed the "hobbit", disappeared about 50,000 years ago, much earlier than the 12,000 years ago estimated initially.[92][93]
- A study by MIT predicts that much of Asia will be at high risk of severe water stress by 2050, with an extra billion more people becoming water stressed compared to today.[94]
- 31 مارس – Astronomers report the discovery of a unique white dwarf star – designated SDSSJ124043.01+671034.68 – which has a 99.9 percent oxygen atmosphere.[95]
أبريل
- 1 أبريل – A study by the University of Southern California concludes that drinking even moderate amounts of coffee can significantly reduce the risk of developing colorectal cancer.[96]
- 4 أبريل
- Researchers found the fossil of Aquilonifer spinosus covered in carbonate from a formation called the Herefordshire Lagerstätte in UK.[97]
- A new quantum state of matter is discovered in a graphene-like magnetic material RuCl3 hosting curious magnetic quasiparticles called Majorana fermions which are their own antiparticles. It is a step forward in materials which will allow quantum computation.[99][100]
- 7 أبريل
- A new analysis of clouds and their role in global warming reveals they contain more liquid water (as opposed to ice) than previously thought. This makes them less reflective and therefore results in more heat reaching the Earth's surface, meaning that future temperature increases may have been underestimated.[101]
- A new method to produce transistors is presented, based on nanocrystal 'inks'. This allows them to be produced on flexible surfaces, possibly with 3D printers.[102]
- 8 أبريل – SpaceX successfully lands the first stage of a Falcon 9 rocket (SpaceX CRS-8) on a floating drone ship for the first time.[98][103]
- 9 أبريل – By adding a one-atom thick layer of graphene to solar panels, Chinese scientists report that electricity can be generated from raindrops.[104]
- 11 أبريل – Scientists announce an updated biological "tree of life" summarizing the evolution of all known life forms, and find that the branches of the new overview, based on the latest genetic findings, are mainly composed of bacteria.[105][106][107]
- 12 أبريل – Scientists announce Breakthrough Starshot, a Breakthrough Initiatives program, to develop a proof-of-concept fleet of small centimeter-sized light sail spacecraft, named StarChip,[108] capable of making the journey to Alpha Centauri, the nearest extrasolar star system, at speeds of 20%[109][110] and 15%[111] of the speed of light, taking between 20 and 30 years to reach the star system, respectively, and about 4 years to notify Earth of a successful arrival.
- 13 أبريل
- A quadriplegic man, Ian Burkhart from Ohio, is able to perform complex functional movements with his fingers after a chip was implanted in his brain.[112][113]
- Astronomers report the discovery of Crater 2, the fourth largest satellite galaxy of the Milky Way, at a distance of 380,000 light years.[114][115]
- An international team reports synthesising ultra-long carbyne inside double-walled nanotubes. This exotic form of carbon is even stronger than graphene.[116][117]
- 14 أبريل – The discovery of hormone asprosin is reported in Cell.[118]
- 21 أبريل – BioViva USA reports the first successful use of gene therapy to extend the length of telomeres in a human patient.[120]
- 22 أبريل
- اكتشاف quantum tunneling of water molecules is reported.[121]
- Scientists announce the discovery of an extensive reef system near the Amazon River, covering an estimated 3,600 square miles (9,300 km2).[119]
- 26 أبريل – Astronomers using the Hubble Space Telescope report the discovery of a moon orbiting the remote dwarf planet Makemake.[122][123]
- 28 أبريل
- Scientists identify a pair of molecular signals controlling skin and hair colour, which could be targeted by new drugs to treat skin pigment disorders like vitiligo.[124]
- A new paper in Astrobiology suggests there could be a way to simplify the Drake equation, based on observations of exoplanets discovered in the last two decades.[125][126]
- 29 أبريل – A team at Stanford University reveals "OceanOne", a humanoid robot capable of moving around the seabed using thrusters.[127]
مايو
- 2 مايو
- Researchers of the Max Planck Institute for Chemistry and the Cyprus Institute in Nicosia calculate that in future decades, the Middle East and North Africa could become so hot that human habitability is compromised.[128]
- Researchers at the University of Illinois and University of Puerto Rico announce they have sequenced the mitochondrial genome for the Hispaniolan solenodon, a venomous mammal found only on Hispaniola. Their findings confirm that the species diverged from all other living mammals about 78 million years ago, before dinosaurs went extinct.[129]
- Astronomers discover three potentially Earth-like planets in the habitable zone of an ultracool brown dwarf star (TRAPPIST-1) just 40 light years away from Earth.[130]
- A study in PNAS concludes that Earth may be home to 1 trillion species, with 99.999 percent remaining undiscovered.[131]

13 May: Synthesizing a human genome considered,[132] and later, 2 June, formally announced.[133][134]
- 4 مايو – The most detailed ever study of leopard populations reveals that the animals have lost 75% of their historical habitat range since 1750.[135]
- 9 مايو
- A transit of Mercury occurs.
- Oxygen is detected in the Martian atmosphere for the first time in 40 years.[136]
- 10 مايو
- NASA's Kepler mission verifies 1,284 new exoplanets – the single largest finding of planets to date.[137][138][139]
- Samsung announces a 256 gigabyte microSD card.[140]
- 13 مايو – Scientists consider extending the Human Genome Project to include creating a synthetic human genome.[132]
- 16 مايو – NASA confirms that April 2016 was the hottest April ever recorded, beating the previous record set in 2010 by 0.24 °C, the largest margin ever.[141]
- 17 May
- Scientists at IBM Research announce a storage memory breakthrough by reliably storing three bits of data per cell using a new memory technology known as phase-change memory (PCM). The results could provide fast and easy storage to capture the exponential growth of data in the future.[142]
- A detailed report by the National Academies of Sciences, Engineering, and Medicine finds no risk to human health from genetic modifications of food.[143][144]
- Researchers at the University of Virginia Health System find that the Oct4 gene, once thought to be inactive in adults, actually plays a vital role in preventing heart attacks and strokes. The gene could delay at least some of the effects of aging.[145]
- 18 مايو
- At the I/O developer conference, Google reveals it has been working on a new chip, known as the Tensor Processing Unit (TPU), which delivers "an order of magnitude higher performance per watt than all commercially available GPUs and FPGA."[146]
- A study of Totten Glacier, East Antarctica's largest outlet of ice, reveals that its melting could pass a critical threshold within the next century, entering a period of irreversible retreat and ultimately adding nearly three metres to global sea levels.[147][148]
- 19 مايو – Scientists in the US report evidence that tsunamis up to 120m high swept across Mars in the ancient past.[149][150]
- 23 مايو
- India conducts the first successful launch of a new space plane, called the Reusable Launch Vehicle (RLV), which is delivered to a height of 65 kilometres (40 mi).
- Significant asteroid data arising from the Wide-field Infrared Survey Explorer and NEOWISE missions is questioned,[151][152][153] but the criticism did not undergo peer review yet.[154]
- 24 مايو – A survey of 216,000 adolescents from all 50 US states finds the number of teens with marijuana-related problems is declining and marijuana use is falling, despite the fact that more US states are legalising or decriminalising the drug.[155]
- 25 مايو – Researchers discover new evidence that amyloid-beta protein acts as a natural antibiotic in the brain: Alzheimer's-associated amyloid plaques may be a normal part of the immune system, and removing amyloid could actually be harmful.[156][157]
- 26 مايو – Evidence of a recent, extreme ice age on Mars is published in the journal Science. Just 370,000 years ago, the planet would have appeared more white than red, the authors say.[158]
- 27 مايو – Strimvelis, an ex-vivo stem cell gene therapy for adenosine deaminase deficiency, and the first gene therapy for children, is granted regulatory approval by the European Commission.[159]
يونيو
- 1 يونيو
- Worldwide, renewable energy grew at its fastest ever rate in 2015, according to a report by the Renewable Energy Policy Network for the 21st Century (REN21).[160][161]
- Scientists at Rice University characterise how single-molecule "nanocars" move in open air, which they claim will help the kinetics of molecular machines in ambient conditions over time.[162]
- 2 يونيو
- Scientists formally announce HGP-Write, a plan to synthesize the human genome.[133][134]
- A Stanford clinical trial finds that stem cells injected directly into the brain of chronic stroke sufferers revived dead brain circuits and restored patients' ability to walk.[163][164]

14 June: Bramble Cay melomys, reported to be the first recorded mammal to become extinct due to anthropogenic climate change.[165]
- 3 يونيو
- NASA and ESA jointly announce that the Universe is expanding 5% to 9% faster than previously thought, after using the Hubble Space Telescope to measure the distance to stars in 19 galaxies beyond the Milky Way.[166]
- A new combination of chemotherapy drugs for pancreatic cancer, presented at the world's biggest cancer conference, shows long-term survival could be increased from 16% to 29%.[167][168]
- 7 يونيو – The National Snow and Ice Data Center reports that the Arctic sea ice extent was the lowest on record for May by an unusually wide margin.[169][170]
- 8 يونيو – The IUPAC proposes the final names of four new chemical elements on the periodic table: nihonium, moscovium, tennessine, and oganesson.[171]
- 9 يونيو – A way of pumping CO 2 underground and turning it from a gas into solid carbonate minerals is demonstrated in Iceland, offering a potentially better method of carbon capture and storage.[172][173]
- 13 June – Researchers at the University of Cambridge demonstrate a hybrid of excited molecules and molecules plus emitted light, created at room temperature.[174]
- 14 June – Researchers from Queensland's Department of Environment and Heritage Protection, and the University of Queensland jointly report that the Bramble Cay melomys is likely extinct, adding: "Significantly, this probably represents the first recorded mammalian extinction due to anthropogenic climate change."[165]
- 15 يونيو
- Scientists announce detecting a second gravitational wave event (GW151226) resulting from the collision of black holes.[175]
- NASA astronomers announce the discovery of 2016 HO3 (also written 2016 HO3), an asteroid first observed on 27 April 2016, that is considered the best and most stable example to date of a constant near-Earth companion, or "quasi-satellite" of Earth.[176]
- 16 June – Researchers at Massachusetts General Hospital announce a new method for long-term culturing of adult stem cells.[177]
- 20 يونيو
- China introduces the Sunway TaihuLight, the world's fastest supercomputer, capable of 93 petaflops and a peak performance of 125 petaflops.[178]
- Astronomers discover that the galaxy Dragonfly 44 consists of 99.99% dark matter, much more than in all other known galaxies.[179][180]
- 23 يونيو – Dutch scientists announce that crops of four vegetables and cereals grown in soil similar to that on Mars are safe to eat.[181]
- 29 يونيو – NASA scientists report that the bright spot in Occator crator on the dwarf planet Ceres may be mostly sodium carbonate (Na 2CO 3).[182]
- 30 يونيو – The first known death caused by a self-driving car is disclosed by Tesla Motors.[183]
يوليو
- 1 يوليو – A new family of tetraquark particles – named X(4140), X(4274), X(4500), and X(4700) – is announced by researchers at the Large Hadron Collider.[184]
- 4 يوليو – NASA scientists announce the arrival of the Juno spacecraft at the planet Jupiter.[185][186]
- 11 يوليو – Astronomers announce the discovery of 2015 RR245, a dwarf planet candidate in the Kuiper Belt with a highly elliptical 700-year orbit.[187][188]
- 13 يوليو – U.S. and Indian scientists report that graphene-infused packaging is a million times better at blocking moisture than typical plastic.[189]
- 20 يوليو
- Using the Hubble telescope, scientists perform the first spectroscopy of the atmospheres of Earth-sized exoplanets (orbiting TRAPPIST-1).[191][192]
- Scientists at Rice University announce a new titanium-gold alloy that is four times harder than most steels.[193]
- 21 يوليو – The hottest ever temperature in the Eastern Hemisphere is reported, with Mitribah, Kuwait reaching 54 °C (129.2 °F).[194] This is second only to Death Valley in California, which saw 56.7 °C (134.1 °F) in 1913.
- 25 يوليو
- Scientists report identifying a set of 355 genes from the Last Universal Common Ancestor (LUCA) of all organisms living on Earth.[190]
- Sex hormones can stimulate production of telomerase, an enzyme naturally found in the human organism, new research shows.[195]
- 26 يوليو – Solar Impulse 2 becomes the first solar-powered aircraft to circumnavigate the Earth.[196]
- 27 يوليو
- Neonicotinoids, the world’s most widely used insecticide, are found to reduce bee sperm counts by almost 40%, as well as cutting the lifespan of bee drones by a third.[197]
- Researchers in Germany discover that bacteria from the human nose تنتج مضاد حيوي مبتكر which is effective against multiresistant pathogens.[198][199]
- Current levels of atmospheric greenhouse gases already commit the planet to air temperatures over many land regions being eventually warmed by greater than 1.5 degrees Celsius, according to new research.[200][201]
- 28 يوليو – A new "vortex" laser that travels in a corkscrew pattern is shown to carry 10 times or more the information of conventional lasers, potentially offering a way to extend Moore's Law.[202]
- 29 يوليو – The seafloor in the Clarion-Clipperton Zone – an area in the Pacific Ocean being targeted for deep-sea mining – is found to contain an abundance and diversity of life, with more than half of the species collected being new to science.[203]
أغسطس
- 1 أغسطس – Using the DNA from over 450,000 customers of gene-testing company 23andMe, researchers identify for the first time 15 regions of the genome associated with depression.[204][205]
- 3 أغسطس – Researchers pinpoint which of the more than 4,000 exoplanet candidates discovered by NASA's Kepler mission are most likely to be similar to Earth. Their research outlines 216 Kepler planets located within the 'habitable zone', of which 20 are the best candidates to be habitable rocky planets like Earth.[206][207]
- 4 August – A team at the University of Oxford achieves a quantum logic gate with record-breaking 99.9% precision, reaching the benchmark required to build a quantum computer.[208]
- 5 أغسطس
- Analysis of an increased dataset at the Large Hadron Collider suggests that the 750 GeV diphoton excess observed in 2015[209][210][211] was probably just a statistical fluctuation.[212][213]
- Research by Imperial College London suggests that a new form of light can be created by binding it to a single electron, combining the properties of both.[214]

11 August: Greenland shark found to be the longest-lived vertebrate on Earth, capable of living nearly 400 years.[215]
- 6 August – Engineers at the University of California, Berkeley, create the first dust-sized wireless sensors that may be implanted within the body.[216]
- 8 August – New research by Stanford University suggests that phase-change memory can be engineered to be 1,000 times faster, while using less energy and requiring less space.[217]
- 11 أغسطس
- Venus may have been habitable in the ancient past, with a shallow liquid-water ocean and much lower temperatures than today, according to NASA climate models.[218]
- The Greenland shark (Somniosus microcephalus) is found to be the longest-lived vertebrate, able to reach a lifespan of nearly 400 years.[215]
- 12 August – Researchers at University College London devise a software algorithm able to scan and replicate almost anyone's handwriting.[219][220]
- 15 أغسطس
- NASA reports that July 2016 was the hottest single month in recorded history (going back to 1880), at 1.51 degrees Fahrenheit (0.84 degrees Celsius) above the 1950-1980 global average.[221]
- NASA confirms that fracking is responsible for a huge methane hot spot in the United States.[222][223]
- A possible new subatomic particle could provide evidence of a fifth fundamental force of nature, according to research published in Physical Review Letters by scientists at the University of California, Irvine.[224]
- Replacing tropical lowland forests with palm oil plantations can damage 11 out of 14 functions of a healthy ecosystem, some of which will be irreparable, concludes a study by the Helmholtz Centre For Environmental Research.[225]
- 16 August – MIT announces a breakthrough which can double lithium-ion battery capacity.[226]
- 22 August – Researchers at Princeton demonstrate an open source 25-core chip that can easily be scaled to create a 200,000-core computer.[227][228]

24 August: Artist's impression of Proxima b, an Earth-sized exoplanet detected in the habitable zone of Proxima Centauri, the closest star to the Sun - possible destination of the StarChip spacecraft.[229]
- 24 August – Astronomers announce the detection of Proxima b, an Earth-sized exoplanet that is in the habitable zone of the red dwarf star Proxima Centauri, the closest star to the Sun.[229] Due to its closeness to Earth, Proxima b may be a flyby destination for a fleet of interstellar StarChip spacecrafts currently being developed by the Breakthrough Starshot project.[229]
- 25 August – Astronomers report that Dragonfly 44, an ultra diffuse galaxy (UDG) with the mass of the Milky Way galaxy, but with nearly no discernable stars or galactic structure, might be made almost entirely of dark matter.[230][231][232]
- 26 August – The University of Washington and The Nature Conservancy publish an animated map showing where mammals, birds and amphibians are projected to move in the Western Hemisphere in response to climate change.[233]
- 27 August – NASA's Juno probe makes a close pass of Jupiter, coming within 4،200 km (2،600 mi) of the cloud tops – the closest any spacecraft has ever approached the gas giant without entering its atmosphere.[234]
- 28 أغسطس
- HI-SEAS IV, the latest Hawaii Space Exploration Analog and Simulation, an experiment to simulate a human colony on Mars, concludes after exactly one year.[235][236]
- DNA is sequenced in outer space for the first time, with NASA astronaut Kate Rubins using a MinION device aboard the International Space Station.[237]
- 31 أغسطس
- The world's oldest known fossils, which may be stromatolites, are claimed to have been found on a wavy rock feature in southwestern Greenland, possibly dating back 3.7 billion years.[238][239]
- Aducanumab, a new antibody, is shown to significantly reduce harmful beta-amyloid plaques in patients with early-stage Alzheimer's disease.[240]
سبتمبر
- 1 September – An annular solar eclipse occurs.
- 2 September – Carbon nanotube transistors are shown to outperform silicon for the first time.[241]
- 4 September – The International Union for Conservation of Nature and Natural Resources (IUCN) changes the status of the giant panda from "endangered" to "vulnerable" after decades of conservation work.[242] However, the Eastern Gorilla – the largest living primate – is listed as Critically Endangered.[243]
- 5 سبتمبر
- Philae, the lander of ESA's Rosetta spacecraft, is located on the comet 67P/Churyumov–Gerasimenko; the exact position of the probe was not known earlier since its landing on the comet in November 2014.[244][245]
- Typhoons in East Asia have grown 50% stronger in the past 40 years due to warming seas, according to a new study.[246]

14 سبتمبر: Reddish north pole of Charon, moon of Pluto, made of tholins formed from atmospheric gases released from Pluto.[247]
- 7 سبتمبر – One-tenth of the world's wilderness is reported to have disappeared in the last 20 years – an area twice the size of Alaska – with the Amazon and Central Africa being the hardest hit regions.[248][249][250]
- 8 سبتمبر
- DNA testing of skeletal remains in London confirms that Yersinia pestis was the bacteria responsible for the Great Plague of 1665.[251]
- NASA launches the seven-year OSIRIS-REx mission, which aims to reach the 500m-wide asteroid Bennu and bring a sample back to Earth.[252][253][254][255]
- A genetic analysis shows that the genus giraffe, previously thought to contain one extant species, actually consists of four.[256]
- 10 September – The second largest meteorite ever found is exhumed near Gancedo, Argentina. It weighs 30 tonnes and fell to Earth around 2000 BC.[257]
- 13 September – The European Space Agency releases the first batch of data from the Gaia space telescope, which has recorded the position and brightness of a billion stars in the Milky Way galaxy.[258][259]
- 14 September – Astronomers announce that the reddish-brown cap of the north pole of Charon, the largest of five moons that orbit the dwarf planet Pluto, is composed of tholins, organic macromolecules produced from methane, nitrogen and related gases released from the atmosphere of Pluto and transferred over about 19،000 km (12،000 mi) distance to the orbiting moon.[247]
- 16 September – The development of 1 terabit-per-second transmission rates over optical fiber is announced by Nokia Bell Labs, Deutsche Telekom T-Labs and the Technical University of Munich.[260]
- 20 September
- Sandisk announces the first 1 terabyte SD card at photokina 2016.[261]
- A Japanese team accurately sequences a tardigrade genome, finds minimal foreign DNA, and discovers a protein that confers resistance to radiation when transferred into human cells.[262][263]

21 September: All non-African humans currently on Earth can be traced to a single group that exited Africa about 50,000 years ago.[264]
- 21 September – Scientists report that, based on human DNA genetic studies, all non-African humans in the world today can be traced to a single population that exited Africa between 50,000 and 80,000 years ago.[264]
- 22 سبتمبر
- Meltwater ponds are reported in East Antarctica for the first time, after temperatures rose above 0 °C.[265]
- Researchers at the University of Toronto create the first map that shows the global genetic interaction network of a cell. It begins to explain how thousands of genes coordinate with one another to orchestrate cellular life.[266]
- 25 September – The Five-hundred-meter Aperture Spherical Telescope (FAST) becomes operational in Guizhou Province, southwest China.[267]
- 26 September – Mercury is found to be tectonically active.[268]
- 27 سبتمبر
- 29 September – A study led by the University of Cambridge finds that body-worn cameras led to a 93% drop in complaints made against police by the UK and US public.[272]
- 30 September – The Rosetta spacecraft ends its mission by attempting a soft-landing inside a 130 m (425 ft) wide pit, called Deir el-Medina, on comet 67P. The walls of the pit contain 0.91 m (3 ft) wide so-called "goose bumps", considered to be building blocks of the comet.[273][274][275]
أكتوبر
- 3 أكتوبر
- A study published by the University of Wisconsin-Milwaukee shows that caffeine consumption may reduce the risk of dementia in women by 36 percent.[278]
- The 2016 Nobel Prize in Physiology or Medicine is awarded to Yoshinori Ohsumi of Japan for discoveries about autophagy.[279]
- 4 October – The 2016 Nobel Prize in Physics is awarded to David J. Thouless, F. Duncan M. Haldane and John M. Kosterlitz for discoveries relating to exotic quantum states of matter and topological order.[280]
- 5 أكتوبر
- The 2016 Nobel Prize in Chemistry is awarded to Jean-Pierre Sauvage, Sir J. Fraser Stoddart and Bernard L. Feringa for the design and synthesis of molecular machines.[281][282]
- Scientists report that the upper age limit of human longevity is 115 years old.[276][277]
- NASA's Cassini mission reveals evidence of a subsurface ocean within Saturn's moon Dione.[283]
- 6 أكتوبر
- Researchers at France's CNRS research institute announce that Proxima b may have oceans.[284]
- Researchers at the Department of Energy's Lawrence Berkeley National Laboratory demonstrate a working 1 nanometre (nm) transistor.[285]
- 9 October – Nivolumab is shown to more than double the one-year survival rate of patients with head and neck cancer compared with chemotherapy. It also shrinks tumours in advanced kidney cancer patients.[286]
الأحداث المتوقعة والمزمعة
أكتوبر
- 19 October – ExoMars Trace Gas Orbiter arrives at Mars, Schiaparelli lands on Mars.
غير معروفة التاريخ
- The advanced Virgo detector starts looking for gravitational waves in autumn 2016.
الوفيات
- 16 August – Jemma Redmond, Irish biochemist, pioneer of 3D bioprinting (و. 1978)[287]
انظر أيضاً
الهامش
- ^ "International Years". United Nations. Retrieved 2015-12-26.
- ^ "Breakthrough achieved in Ceramics 3D Printing Technology". HRL. 1 January 2016. Retrieved 1 January 2016.
- ^ "Human-machine superintelligence can solve the world's most dire problems". EurekAlert!. 1 January 2016. Retrieved 1 January 2016.
- ^ أ ب "Most distant massive galaxy cluster identified". MIT. 7 January 2016. Retrieved 12 January 2016.
- ^ Zimmer, Carl (7 January 2016). "Genetic Flip Helped Organisms Go From One Cell to Many". New York Times. Retrieved 7 January 2016.
- ^ Erwin, Douglas H. (9 November 2015). "Early metazoan life: divergence, environment and ecology". Phil. Trans. R. Soc. B. 370 (20150036): 20150036. doi:10.1098/rstb.2015.0036. Retrieved 7 January 2016.
- ^ "Earliest tea as evidence for one branch of the Silk Road across the Tibetan Plateau". Nature. 6: 18955. 7 January 2016. Bibcode:2016NatSR...618955L. doi:10.1038/srep18955. Retrieved 11 January 2016.
{{cite journal}}: Cite uses deprecated parameter|authors=(help) - ^ Chang, Kenneth (21 January 2016). "New Biggest Prime Number = 2 to the 74 Mil ... Uh, It's Big". New York Times. Retrieved 22 January 2016.
- ^ Cooper, Curtis (7 January 2016). "Mersenne Prime Number discovery - 274207281-1 is Prime!". Mersenne Research, Inc. Retrieved 22 January 2016.
- ^ "Too much sugar? There's an enzyme for that". EurekAlert!. 11 January 2016. Retrieved 12 January 2016.
- ^ "Human-made climate change suppresses the next ice age". EurekAlert!. 13 January 2016. Retrieved 14 January 2016.
- ^ "Water ice found on the surface of comet 67P". PhysOrg. 14 January 2016. Retrieved 14 January 2016.
- ^ "The world's first 13TB SSD is here". PC World. 13 January 2016. Retrieved 15 January 2016.
- ^ "What is 10 miles across, but powers an explosion brighter than the Milky Way?". EurekAlert!. 14 January 2016. Retrieved 15 January 2016.
- ^ "Colossal star explosion detected". BBC. 14 January 2016. Retrieved 15 January 2016.
- ^ "Jason ocean height mission blasts off". BBC. 17 January 2016. Retrieved 17 January 2016.
- ^ أ ب Brown, Dwayne; Cabbage, Michael; McCarthy, Leslie; Norton, Karen (20 January 2016). "NASA, NOAA Analyses Reveal Record-Shattering Global Warm Temperatures in 2015". NASA. Retrieved 21 January 2016.
- ^ "Man-made heat put in oceans has doubled since 1997, study finds". PhysOrg. 18 January 2016. Retrieved 19 January 2016.
- ^ "Industrial-era global ocean heat uptake doubles in recent decades". Nature Climate Change. 18 January 2016. Retrieved 19 January 2016.
- ^ "Light-activated nanoparticles prove effective against antibiotic-resistant "superbugs"". University of Colorado. 18 January 2016. Retrieved 19 January 2016.
- ^ "Tiny electronic implants monitor brain injury, then melt away". Science Daily. 18 January 2016. Retrieved 20 January 2016.
- ^ "Head transplant carried out on monkey, claims maverick surgeon". New Scientist. 19 January 2016. Retrieved 20 January 2016.
- ^ "Bridging the Bio-Electronic Divide". DARPA. 19 January 2016. Retrieved 22 January 2016.
- ^ "Astronomers say a Neptune-sized planet lurks beyond Pluto". Science. 20 January 2016. Retrieved 20 January 2016.
- ^ Chang, Kenneth (20 January 2016). "Ninth Planet May Exist Beyond Pluto, Scientists Report". New York Times. Retrieved 22 January 2016.
- ^ "Analyses reveal record-shattering global warm temperatures in 2015". NASA. 20 January 2016. Retrieved 20 January 2016.
- ^ "Climate change: 2015 'shattered' global temperature record by wide margin". BBC. 20 January 2016. Retrieved 20 January 2016.
- ^ "The telescope gets its first major upgrade in centuries". Lockheed Martin. 23 January 2016. Retrieved 24 January 2016.
- ^ أ ب "Bringing time and space together for universal symmetry". PhysOrg. 28 January 2016. Retrieved 29 January 2016.
- ^ "New handheld, pen-sized microscope could ID cancer cells in doctor's offices and operating rooms". University of Washington. 25 January 2016. Retrieved 27 January 2016.
- ^ "Cancer riddle, solved". University of Iowa. 25 January 2016. Retrieved 27 January 2016.
- ^ "Global nitrogen footprint mapped for first time". University of Sydney. 25 January 2016. Retrieved 27 January 2016.
- ^ "Australian scientists to begin trialling fully implantable bionic eye". Science Alert. 25 January 2016. Retrieved 29 January 2016.
- ^ "Google AI algorithm masters ancient game of Go". Nature. 27 January 2016. Retrieved 28 January 2016.
- ^ "AlphaGo: using machine learning to master the ancient game of Go". Google. 27 January 2016. Retrieved 27 January 2016.
- ^ "Google achieves AI 'breakthrough' by beating Go champion". BBC. 27 January 2016. Retrieved 27 January 2016.
- ^ "Monstrous Cloud Boomerangs Back to Our Galaxy". HubbleSite. 28 January 2016. Retrieved 29 January 2016.
- ^ "Graphene shown to safely interact with neurons in the brain". PhysOrg. 29 January 2016. Retrieved 30 January 2016.
- ^ "Proton beam cancer therapy 'effective with fewer side effects'". BBC. 30 January 2016. Retrieved 30 January 2016.
- ^ "Long-term toxic effects of proton radiotherapy for paediatric medulloblastoma: a phase 2 single-arm study". The Lancet. 29 January 2016. Retrieved 30 January 2016.
- ^ "Moon was produced by a head-on collision between Earth and a forming planet". UCLA. 28 January 2016. Retrieved 1 February 2016.
- ^ Gallagher, James (1 February 2016). "Scientists get 'gene editing' go-ahead". BBC News. BBC. Retrieved 1 February 2016.
- ^ Cheng, Maria (1 February 2016). "Britain approves controversial gene-editing technique". AP News. Retrieved 1 February 2016.
- ^ "Smallest lattice structure worldwide". Science Daily. 2 February 2016. Retrieved 3 February 2016.
- ^ "Nuclear Fusion Hits a Massive Milestone in Germany". VICE. Retrieved 5 February 2016.
- ^ "Nuclear fusion device's 1st test with hydrogen declared a success". CBC. Retrieved 5 February 2016.
- ^ أ ب "Gravitational Waves Detected 100 Years After Einstein's Prediction". LIGO. 11 February 2016. Retrieved 13 February 2016.
- ^ أ ب Abbott, B.P.; et al. (2016). "Observation of Gravitational Waves from a Binary Black Hole Merger". Phys. Rev. Lett. 116 (6): 061102. Bibcode:2016PhRvL.116f1102A. doi:10.1103/PhysRevLett.116.061102.
- ^ أ ب Overbye, Dennis (11 February 2016). "Physicists Detect Gravitational Waves, Proving Einstein Right". New York Times. Retrieved 11 February 2016.
- ^ أ ب The Editorial Board (16 February 2016). "The Chirp Heard Across the Universe". New York Times. Retrieved 16 February 2016.
- ^ "January hits new record low in the Arctic". National Snow and Ice Data Center. 4 February 2016. Retrieved 13 February 2016.
- ^ "New cryopreservation procedure wins Brain Preservation Prize". KurzweilAI. 9 February 2016. Retrieved 11 February 2016.
- ^ "Opinion: The prize win is a vindication of the idea of cryonics, not of unaccountable cryonics service organizations". The Brain Preservation Foundation. 9 February 2016. Retrieved 11 February 2016.
- ^ Krauss, Lawrence (11 February 2016). "Finding Beauty in the Darkness". New York Times. Retrieved 11 February 2016.
- ^ "Earth's rarest minerals catalogued". BBC. 13 February 2016. Retrieved 13 February 2016.
- ^ "For a special Valentine? Beyond diamonds and gems: The world's rarest minerals". EurekAlert. 12 February 2016. Retrieved 13 February 2016.
- ^ "Eternal 5D data storage could record the history of humankind". University of Southampton. 15 February 2016. Retrieved 17 February 2016.
- ^ "Scientists report "unprecedented" success using T-cells to treat cancer". Science Alert. 15 February 2016. Retrieved 18 February 2016.
- ^ Staff (16 February 2016). "First detection of super-earth atmosphere". Phys.org. Retrieved 17 February 2016.
- ^ "Animals revived after being in a frozen state for over 30 years". Science Daily. 16 February 2016. Retrieved 17 February 2016.
- ^ Tsujimoto, Megumu; Imura, Satoshi; Kanda, Hiroshi (2015). "Recovery and reproduction of an Antarctic tardigrade retrieved from a moss sample frozen for over 30 years". Cryobiology. 72 (1): 78–81. doi:10.1016/j.cryobiol.2015.12.003. PMID 26724522.
- ^ St. Fleur, Nicholas (19 February 2016). "Two Naked Mole Rats, Seemingly Immune to Cancer, Got Cancer". New York Times. Retrieved 20 February 2016.
- ^ أ ب "Major insight into killer pancreatic cancer". BBC. 24 February 2016. Retrieved 24 February 2016.
- ^ "Atlas, The Next Generation". YouTube. 23 February 2016. Retrieved 24 February 2016.
- ^ "Pancreatic cancer is 4 diseases, each with new treatment possibilities". EurekAlert. 24 February 2016. Retrieved 24 February 2016.
- ^ "Solar cells as light as a soap bubble". EurekAlert. 26 February 2016. Retrieved 29 February 2016.
- ^ "Global and regional health effects of future food production under climate change: a modelling study". The Lancet. 2 March 2016. Retrieved 3 March 2016.
- ^ "More than half a million could die as climate change impacts diet – report". The Guardian. London. 3 March 2016. Retrieved 3 March 2016.
- ^ "Hubble sets new cosmic distance record". BBC News. 3 March 2016. Retrieved 5 March 2016.
- ^ "Our Hemisphere's Temperature Just Reached a Terrifying Milestone". Slate. 3 March 2016. Retrieved 6 March 2016.
- ^ "The mercury doesn't lie: We've hit a troubling climate change milestone". Boston Globe. 5 March 2016. Retrieved 6 March 2016.
- ^ "Scientists develop very early stage human stem cell lines for first time". University of Cambridge. 4 March 2016. Retrieved 6 March 2016.
- ^ "Mutated gene safeguards against heart attacks". EurekAlert. 7 March 2016. Retrieved 8 March 2016.
- ^ Clark, Stephen (9 March 2016). "InSight Mars lander escapes cancellation, aims for 2018 launch". Spaceflight Now. Retrieved 2016-03-09.
- ^ Chang, Kenneth (9 March 2016). "NASA Reschedules Mars InSight Mission for May 2018". New York Times. Retrieved 9 March 2016.
- ^ "Google's AI beats world Go champion in first of five matches". BBC News. 9 March 2016. Retrieved 9 March 2016.
- ^ أ ب "Mars methane mission lifts off". BBC News. 14 March 2016. Retrieved 14 March 2016.
- ^ "CO2 data is 'wake-up call' for Paris climate deal". BBC News. 10 March 2016. Retrieved 11 March 2016.
- ^ "A bacterium that degrades and assimilates poly(ethylene terephthalate)". Science. 11 March 2016. Retrieved 11 March 2016.
- ^ "Could a new plastic-eating bacteria help combat this pollution scourge?". The Guardian. 10 March 2016. Retrieved 11 March 2016.
- ^ "Pregnant T-rex discovery sheds light on evolution of egg-laying". ABC. 17 March 2016. Retrieved 17 March 2016.
- ^ "Future brain therapies for Parkinson's possible with stem cell bioengineering innovation". EurekAlert. 17 March 2016. Retrieved 17 March 2016.
- ^ Zimmer, Carl (17 March 2016). "Humans Interbred With Hominins on Multiple Occasions, Study Finds". The New York Times. Retrieved 17 March 2016.
- ^ "Stem cell therapy reverses age-related osteoporosis in mice". Science Daily. 17 March 2016. Retrieved 25 March 2016.
- ^ أ ب "Carbon emission release rate 'unprecedented' in past 66m years". The Guardian. 21 March 2016. Retrieved 22 March 2016.
- ^ "Scientists find gene responsible for sleep deprivation and metabolic disorders". Science Daily. 24 March 2016. Retrieved 24 March 2016.
- ^ "Fish Walks, Climbs Waterfalls Like a Salamander". Discovery. 24 March 2016. Retrieved 25 March 2016.
- ^ "Creation of minimal cell with just the genes needed for independent life". Science Daily. 24 March 2016. Retrieved 25 March 2016.
- ^ "This man-made cell has the smallest genome ever — but a third of its genes are a mystery". The Washington Post. 25 March 2016. Retrieved 25 March 2016.
- ^ "A biosensor that's 1 million times more sensitive". KurzweilAI. 29 March 2016. Retrieved 1 April 2016.
- ^ "Sea-level rise could nearly double over earlier estimates in next 100 years". Science Daily. 30 March 2016. Retrieved 30 March 2016.
- ^ Ritter, Malcolm (30 March 2016). "Study: Indonesia "hobbit" fossils older than first thought". AP News. Retrieved 1 April 2016.
- ^ Sutikna, Thomas; Tocheri, Matthew W.; et al. (30 March 2016). "Revised stratigraphy and chronology for Homo floresiensis at Liang Bua in Indonesia". Nature. 532 (7599): 366–9. Bibcode:2016Natur.532..366S. doi:10.1038/nature17179. PMID 27027286. Retrieved 1 April 2016.
- ^ "Water problems in Asia's future?". MIT. 30 March 2016. Retrieved 2 April 2016.
- ^ "Newly Discovered Star Has an Almost Pure Oxygen Atmosphere". Popular Mechanics. 31 March 2016. Retrieved 1 April 2016.
- ^ "Coffee consumption linked to decreased risk of colorectal cancer". Science Daily. 1 April 2016. Retrieved 3 April 2016.
- ^ Cassie Martin. "Ancient arthropod kept its brood close". Science News.
- ^ أ ب "SpaceX makes historic rocket landing". CNN. 9 April 2016. Retrieved 9 April 2016.
- ^ Banerjee, A.; et al. (2016). "Proximate Kitaev quantum spin liquid behaviour in a honeycomb magnet". Nature Materials. 15 (7): 733–740. doi:10.1038/nmat4604.
- ^ "New bizarre state of matter seems to split fundamental particles". CBS News. 7 April 2016. Retrieved 8 April 2016.
- ^ "Global warming may be far worse than thought, cloud analysis suggests". The Guardian. 7 April 2016. Retrieved 8 April 2016.
- ^ "First transistors made entirely of nanocrystal 'inks'". 2016-04-07. Retrieved 2016-04-11.
- ^ "SpaceX on Twitter". Twitter.
- ^ "Future Solar Panels Will Generate Energy From Raindrops". Science News Journal. 9 April 2016. Retrieved 9 April 2016.
- ^ Zimmer, Carl (11 April 2016). "Scientists Unveil New 'Tree of Life'". New York Times. Retrieved 11 April 2016.
- ^ Taylor, Ashley P. (11 April 2016). "Branching Out: Researchers create a new tree of life, largely comprised of [[[كذا|ك]]] mystery bacteria". The Scientist. Retrieved 11 April 2016.
{{cite web}}: URL–wikilink conflict (help) - ^ Hug, Laura A.; Baker, Brett J.; Anantharaman, Karthik; et al. (11 April 2016). "A new view of the tree of life". Nature Microbiology. 1 (5): 16048. doi:10.1038/nmicrobiol.2016.48. Retrieved 11 April 2016.

- ^ Gilster, Paul (12 أبريل 2016). "Breakthrough Starshot: Mission to Alpha Centauri". Centauri Dreams. Retrieved 14 April 2016.
- ^ Overbye, Dennis (12 April 2016). "A Visionary Project Aims for Alpha Centauri, a Star 4.37 Light-Years Away". New York Times. Retrieved 12 April 2016.
- ^ Stone, Maddie (12 April 2016). "Stephen Hawking and a Russian Billionaire Want to Build an Interstellar Starship". Gizmodo. Retrieved 12 April 2016.
- ^ Staff (12 April 2016). "Breakthrough Starshot". Breakthrough Initiatives. Retrieved 12 April 2016.
- ^ "Device Allows Paralyzed Man To Swipe Credit Card, Perform Other Movements". Wexner Medical Center. 13 April 2016. Retrieved 14 April 2016.
- ^ "Implant lets paralysed man 'play guitar'". BBC News. 13 April 2016. Retrieved 14 April 2016.
- ^ "The feeble giant. Discovery of a large and diffuse Milky Way dwarf galaxy in the constellation of Crater". Monthly Notices of the Royal Astronomical Society. 13 April 2016. Retrieved 19 April 2016.
- ^ "Never-before-seen galaxy spotted orbiting the Milky Way". New Scientist. 14 April 2016. Retrieved 19 April 2016.
- ^ "Ultra-long, one-dimensional carbon chains are synthesized for the first time". Science Daily. 13 April 2016. Retrieved 22 April 2016.
- ^ "Scientists have finally made a substance that's even stronger than graphene". inhabitat. 14 April 2016. Retrieved 22 April 2016.
- ^ "Asprosin, a Fasting-Induced Glucogenic Protein Hormone" (PDF). Cell. April 14, 2016. Retrieved 18 April 2016.
{{cite web}}: Cite uses deprecated parameter|authors=(help) - ^ أ ب "Scientists, including UGA researcher, discover new reef system at mouth of Amazon River". University of Georgia. 22 April 2016. Retrieved 27 April 2016.
- ^ "First gene therapy successful against human aging". EurekAlert!. 21 April 2016. Retrieved 27 April 2016.
- ^ "Quantum Tunneling of Water in Beryl: A New State of the Water Molecule". Physical Review Letters. 116 (16): 167802. 22 April 2016. Bibcode:2016PhRvL.116p7802K. doi:10.1103/PhysRevLett.116.167802. Retrieved 23 April 2016.
{{cite journal}}: Cite uses deprecated parameter|authors=(help) - ^ "Hubble discovers moon orbiting the dwarf planet Makemake". EurekAlert!. 26 April 2016. Retrieved 26 April 2016.
- ^ "Hubble Discovers Moon Orbiting the Dwarf Planet Makemake". NASA. 26 April 2016. Retrieved 27 April 2016.
- ^ "Stem cell study finds mechanism that controls skin and hair color". Science Daily. 28 April 2016. Retrieved 29 April 2016.
- ^ "Are we alone? Setting some limits to our planet's uniqueness". Science Daily. 28 April 2016. Retrieved 30 April 2016.
- ^ "Universe Likely Has Many Extinct Civilizations: Study". Discovery. 29 April 2016. Retrieved 30 April 2016.
- ^ "This Robot Mermaid Is The New Way To Explore Oceans". Science Daily. 29 April 2016. Retrieved 30 April 2016.
- ^ "Climate-exodus expected in the Middle East and North Africa". PhysOrg. 2 May 2016. Retrieved 3 May 2016.
- ^ "Endangered venomous mammal predates dinosaurs' extinction, study confirms". University of Illinois at Urbana-Champaign. 2 May 2016. Retrieved 3 May 2016.
- ^ "Three Potentially Habitable Worlds Found Around Nearby Ultracool Dwarf Star". ESO. 2 May 2016. Retrieved 3 May 2016.
- ^ "Researchers find that Earth may be home to 1 trillion species". NSF. 2 May 2016. Retrieved 6 May 2016.
- ^ أ ب Pollack, Andrew (13 May 2016). "Scientists Talk Privately About Creating a Synthetic Human Genome". New York Times. Retrieved 13 May 2016.
- ^ أ ب Pollack, Andrew (2 June 2016). "Scientists Announce HGP-Write, Project to Synthesize the Human Genome". New York Times. Retrieved 2 June 2016.
- ^ أ ب Boeke, Jef D.; et al. (2 June 2016). "The Genome Project–Write". Science (journal). 353 (6295): 126. doi:10.1126/science.aaf6850. Retrieved 2 June 2016.
- ^ "Leopards have lost 75% of their historical habitat". The Guardian. 4 May 2016. Retrieved 5 May 2016.
- ^ "NASA just detected oxygen in the Martian atmosphere". Science Alert. 9 May 2016. Retrieved 10 May 2016.
- ^ "NASA's Kepler Mission Announces Largest Collection of Planets Ever Discovered". NASA. 10 May 2016. Retrieved 10 May 2016.
- ^ "Briefing materials: 1,284 Newly Validated Kepler Planets". NASA. 10 May 2016. Retrieved 10 May 2016.
- ^ Overbay, Dennis (10 May 2016). "Kepler Finds 1,284 New Planets". New York Times. Retrieved 11 May 2016.
- ^ "Samsung announces a massive 256GB microSD card". The Verge. 10 May 2016. Retrieved 11 May 2016.
- ^ "April breaks global temperature record". BBC. 16 May 2016. Retrieved 16 May 2016.
- ^ "IBM Scientists Achieve Storage Memory Breakthrough". IBM. 17 May 2016. Retrieved 17 May 2016.
- ^ "Genetically engineered crops: Experiences and prospects". Science Daily. 17 May 2016. Retrieved 18 May 2016.
- ^ "Genetically Modified Crops Are Safe, Report Says". NBC. 17 May 2016. Retrieved 18 May 2016.
- ^ "Potential 'fountain of youth' gene found". Science Daily. 17 May 2016. Retrieved 23 May 2016.
- ^ "Google's Tensor Processing Unit could advance Moore's Law 7 years into the future". PC World. 18 May 2016. Retrieved 20 May 2016.
- ^ "Scientists predict extensive ice loss from huge Antarctic glacier". EurekAlert!. 18 May 2016. Retrieved 20 May 2016.
- ^ "Evidence of repeated rapid retreat of the East Antarctic ice sheet". EurekAlert!. 18 May 2016. Retrieved 20 May 2016.
- ^ "Evidence of ancient tsunamis on Mars". BBC News. 19 May 2016. Retrieved 20 May 2016.
- ^ "Tsunami waves extensively resurfaced the shorelines of an early Martian ocean". Scientific Reports. 19 May 2016. Retrieved 20 May 2016.
- ^ أ ب Chang, Kenneth (23 May 2016). "How Big Are Those Killer Asteroids? A Critic Says NASA Doesn't Know". New York Times. Retrieved 24 May 2016.
- ^ Myhrvold, Nathan (23 May 2016). "Asteroid thermal modeling in the presence of reflected sunlight with an application to WISE/NEOWISE observational data". arXiv:1605.06490v2.
{{cite journal}}: Cite journal requires|journal=(help) - ^ Billings, Lee (27 May 2016). "For Asteroid-Hunting Astronomers, Nathan Myhrvold Says the Sky Is Falling". Scientific American. Retrieved 28 May 2016.
- ^ NASA Administrator (25 May 2016). "NASA Response to Recent Paper on NEOWISE Asteroid Size Results". NASA. Retrieved 29 May 2016.
- ^ "As more states legalize marijuana, adolescents' problems with pot decline". Science Daily. 24 May 2016. Retrieved 31 May 2016.
- ^ "Human amyloid-beta acts as natural antibiotic in the brain: Alzheimer's-associated amyloid plaques may trap microbes". Science Daily. 25 May 2016. Retrieved 29 May 2016.
- ^ "Harvard researchers unveil new Alzheimer's theory". USA Today. 27 May 2016. Retrieved 29 May 2016.
- ^ "Mars Used To Look More White Than Red". Popular Mechanics. 26 May 2016. Retrieved 28 May 2016.
- ^ "Strimvelis receives European marketing authorisation to treat very rare disease, ADA-SCID". GlaxoSmithKline. 27 May 2016. Retrieved 1 June 2016.
- ^ "Renewable energy surges to record levels around the world". BBC. 1 June 2016. Retrieved 1 June 2016.
- ^ "Renewables 2016 Global Status Report". REN21. 1 June 2016. Retrieved 1 June 2016.
- ^ "Nanocars taken for a rough ride: Single-molecule cars tested in open air". Science Daily. 1 June 2016. Retrieved 2 June 2016.
- ^ "Stem cells shown safe, beneficial for chronic stroke patients, clinical trial finds". EurekAlert!. 2 June 2016. Retrieved 3 June 2016.
- ^ "Stanford medical trial found stem cells injected into the brain aid stroke recovery". ResearchGate. 2 June 2016. Retrieved 3 June 2016.
- ^ أ ب "Revealed: first mammal species wiped out by human-induced climate change". The Guardian. 14 June 2016. Retrieved 15 June 2016.
- ^ Radford, Tim (3 June 2016). "Universe is expanding up to 9% faster than we thought, say scientists". The Guardian. Retrieved 3 June 2016.
- ^ "'Major win' in pancreatic cancer fight". BBC News. 3 June 2016. Retrieved 3 June 2016.
- ^ "Cancer Research UK trial shows improved 5 year survival for pancreatic cancer patients". Cancer Research UK. 3 June 2016. Retrieved 3 June 2016.
- ^ "'We've never seen anything like this': Arctic sea ice hit a stunning new low in May". Washington Post. 7 June 2016. Retrieved 8 June 2016.
- ^ "Low ice, low snow, both poles". NSIDC. 7 June 2016. Retrieved 8 June 2016.
- ^ "IUPAC is naming the four new elements nihonium, moscovium, tennessine, and oganesson". IUPAC. 8 June 2016. Retrieved 12 June 2016.
- ^ "CO2 turned into stone in Iceland in climate change breakthrough". The Guardian. 9 June 2016. Retrieved 11 June 2016.
- ^ "Climate change mitigation: Turning carbon dioxide into rock". Science Daily. 9 June 2016. Retrieved 11 June 2016.
- ^ "Nano 'hall of mirrors' causes molecules to mix with light". University of Cambridge. 13 June 2016. Retrieved 19 June 2016.
- ^ أ ب Overbye, Dennis (15 June 2016). "Scientists Hear a Second Chirp From Colliding Black Holes". New York Times. Retrieved 15 June 2016.
- ^ Agle, DC; Brown, Dwayne; Cantillo, Laurie (15 June 2016). "Small Asteroid Is Earth's Constant Companion". NASA. Retrieved 15 June 2016.
- ^ "New procedure allows long-term culturing of adult stem cells". Science Daily. 16 June 2016. Retrieved 23 June 2016.
- ^ "China builds world's most powerful computer". BBC. 20 June 2016. Retrieved 21 June 2016.
- ^ "Scientists Discover Massive Galaxy Made of 99.99 Percent Dark Matter". 2016-08-25. Retrieved 2016-08-27.
- ^ Pieter van Dokkum; Abraham, Roberto; Brodie, Jean; Conroy, Charlie; Danieli, Shany; Merritt, Allison; Mowla, Lamiya; Romanowsky, Aaron; Zhang, Jielai (2016). "A High Stellar Velocity Dispersion and ~100 Globular Clusters for the Ultra Diffuse Galaxy Dragonfly 44". arXiv:1606.06291 [astro-ph.GA].
- ^ "Dutch crops grown on 'Mars' soil found safe to eat". PhysOrg. 23 June 2016. Retrieved 26 June 2016.
- ^ Landau, Elizabeth; Greicius, Tony (29 June 2016). "Recent Hydrothermal Activity May Explain Ceres' Brightest Area". NASA. Retrieved 30 June 2016.
- ^ "Tesla driver dies in first fatal crash while using autopilot mode". The Guardian. 1 July 2016. Retrieved 1 July 2016.
- ^ "Physicists have discovered what looks like an entire family of new particles in the LHC". Science Alert. 1 July 2016. Retrieved 2 July 2016.
- ^ Chang, Kenneth (5 July 2016). "NASA's Juno Spacecraft Enters Jupiter's Orbit". New York Times. Retrieved 5 July 2016.
- ^ Chang, Kenneth (30 June 2016). "All Eyes (and Ears) on Jupiter". New York Times. Retrieved 1 July 2016.
- ^ "Astronomers discover new distant dwarf planet beyond Neptune". Science Daily. 11 July 2016. Retrieved 12 July 2016.
- ^ Chang, Kenneth (13 July 2016). "Astronomers Discover New Likely Dwarf Planet, the Latest of Many". New York Times. Retrieved 14 July 2016.
- ^ "Graphene-infused packaging is a million times better at blocking moisture". Science Daily. 13 July 2016. Retrieved 14 July 2016.
- ^ أ ب Wade, Nicholas (25 July 2016). "Meet Luca, the Ancestor of All Living Things". New York Times. Retrieved 25 July 2016.
- ^ "First atmospheric study of Earth-sized exoplanets using Hubble telescope". University of Cambridge. 20 July 2016. Retrieved 21 July 2016.
- ^ "A combined transmission spectrum of the Earth-sized exoplanets TRAPPIST-1 b and c". Nature. 20 July 2016. Retrieved 21 July 2016.
- ^ "Titanium + gold = new gold standard for artificial joints". Rice University. 20 July 2016. Retrieved 28 July 2016.
- ^ "Eastern Hemisphere's All-Time Temperature Record: Kuwait Fries in 54°C (129.2°F) Heat". Weather Underground. 22 July 2016. Retrieved 23 July 2016.
- ^ "Male hormone reverses cell aging in clinical trial". Science Daily. 25 July 2016. Retrieved 1 August 2016.
- ^ "Solar Impulse completes historic round-the-world trip". BBC. 26 July 2016. Retrieved 26 July 2016.
- ^ "Leading insecticide cuts bee sperm by almost 40%, study shows". The Guardian. 27 July 2016. Retrieved 27 July 2016.
- ^ "Antibiotics that could fight superbugs produced from bacteria in human nose". The Telegraph. 27 July 2016. Retrieved 27 July 2016.
- ^ "A potential lifesaver lies unrecognized in the human body". Universität Tübingen. 27 July 2016. Retrieved 27 July 2016.
- ^ "Current atmospheric greenhouse gas concentrations likely commit to warmings greater than 1.5C over land". Science Daily. 27 July 2016. Retrieved 31 July 2016.
- ^ "Debate needed on 1.5C temperature target". BBC News. 29 July 2016. Retrieved 31 July 2016.
- ^ "Swirling data: Boosting computing power and info transfer rates tenfold". Science Daily. 28 July 2016. Retrieved 1 August 2016.
- ^ "Abundant and diverse ecosystem found in area targeted for deep-sea mining". EurekAlert. 29 July 2016. Retrieved 31 July 2016.
- ^ "Novel study method identifies 15 genomic regions associated with depression". Science Daily. 1 August 2016. Retrieved 2 August 2016.
- ^ "23andMe Pulls Off Massive Crowdsourced Depression Study". MIT Technology Review. 1 August 2016. Retrieved 2 August 2016.
- ^ "Most likely Earth-like exoplanets cataloged". Science Daily. 3 August 2016. Retrieved 4 August 2016.
- ^ Kane, Stephen R.; Hill, Michelle L.; Kasting, James F.; Ravi Kumar Kopparapu; Quintana, Elisa V.; Barclay, Thomas; Batalha, Natalie M.; Borucki, William J.; Ciardi, David R.; Haghighipour, Nader; Hinkel, Natalie R.; Kaltenegger, Lisa; Selsis, Franck; Torres, Guillermo (1 August 2016). "A Catalog of Kepler Habitable Zone Exoplanet Candidates". arXiv:1608.00620 [astro-ph.EP].
{{cite arXiv}}: Cite has empty unknown parameter:|publisher=(help) - ^ Ballance, C. J.; Harty, T. P.; Linke, N. M.; Sepiol, M. A.; Lucas, D. M. (4 August 2016). "High-Fidelity Quantum Logic Gates Using Trapped-Ion Hyperfine Qubits". Physical Review Letters. Physical Review Letters. 117 (6). doi:10.1103/PhysRevLett.117.060504. Retrieved 7 August 2016.
- ^ Overbye, Dennis (15 December 2015). "Physicists in Europe Find Tantalizing Hints of a Mysterious New Particle". New York Times. Retrieved 15 December 2015.
- ^ Staff (15 December 2015). "Search for new physics in high mass diphoton events in proton-proton collisions at 13 TeV". CMS Collaboration. Retrieved 2 January 2016.
- ^ Staff (15 December 2015). "Search for resonances decaying to photon pairs in 3.2 fb-1 of pp collisions at √s = 13 TeV with the ATLAS detector". ATLAS Collaboration. Retrieved 2 January 2016.
- ^ "Chicago sees floods of LHC data and new results at the ICHEP 2016 conference". 5 August 2015. Retrieved 5 August 2015.
- ^ Overbye, Dennis (5 August 2016). "The Particle That Wasn't". New York Times. Retrieved 5 August 2016.
- ^ "Scientists discover light could exist in a previously unknown form". EurekAlert!. 5 August 2016. Retrieved 6 August 2016.
- ^ أ ب "Longest-lived vertebrate is Greenland shark: Lifespan at least 400 years". Science Daily. 11 August 2016. Retrieved 12 August 2016.
- ^ "Engineers Create The First Dust-Sized Wireless Sensors That Can Be Implanted Into The Human Body". Science News Journal. 6 August 2016. Retrieved 7 August 2016.
- ^ "Stanford-led experiments point toward memory chips 1,000 times faster than today's". Stanford University. 8 August 2016. Retrieved 8 August 2016.
- ^ "NASA Climate Modeling Suggests Venus May Have Been Habitable". NASA. 11 August 2016. Retrieved 11 August 2016.
- ^ "Can a computer copy your handwriting?". BBC News. 12 August 2016. Retrieved 12 August 2016.
- ^ "New computer programme replicates handwriting". UCL. 12 August 2016. Retrieved 12 August 2016.
- ^ "NASA: Last Month Was Earth's Hottest in Recorded History". ABC News. 15 August 2016. Retrieved 16 August 2016.
- ^ "NASA Study Nails Fracking as Source of Massive Methane 'Hot Spot'". Common Dreams. 16 August 2016. Retrieved 17 August 2016.
- ^ "NASA Study Analyzes Four Corners Methane Sources". NASA. 15 August 2016. Retrieved 17 August 2016.
- ^ "Physicists confirm possible discovery of fifth force of nature". PhysOrg. 15 August 2016. Retrieved 16 August 2016.
- ^ "Reduced ecosystem functions in oil palm plantations". Science Daily. 15 August 2016. Retrieved 21 August 2016.
- ^ "Doubling battery power of consumer electronics". MIT. 16 August 2016. Retrieved 19 August 2016.
- ^ "New microchip demonstrates efficiency and scalable design". EurekAlert!. 22 August 2016. Retrieved 26 August 2016.
- ^ "Open source 25-core processor can be stringed into a 200,000-core computer". PC World. 24 August 2016. Retrieved 26 August 2016.
- ^ أ ب ت Chang, Kenneth (24 August 2016). "One Star Over, a Planet That Might Be Another Earth". New York Times. Retrieved 24 August 2016.
- ^ Van Dokkum, Pieter; et al. (25 August 2016). "A High Stellar Velocity Dispersion and ~100 Globular Clusters For The Ultra-Diffuse Galaxy Dragonfly 44". The Astrophysical Journal Letters. 828: L6. doi:10.3847/2041-8205/828/1/L6. Retrieved 27 August 2016.
{{cite journal}}: Explicit use of et al. in:|author=(help)CS1 maint: unflagged free DOI (link) - ^ Hall, Shannon (25 August 2016). "Ghost galaxy is 99.99 per cent dark matter with almost no stars". New Scientist. Retrieved 27 August 2016.
- ^ Feltman, Rachael (26 August 2016). "A new class of galaxy has been discovered, one made almost entirely of dark matter". The Washington Post. Retrieved 26 August 2016.
- ^ "Interactive map shows where animals will move under climate change". University of Washington. 26 August 2016. Retrieved 30 August 2016.
- ^ "Juno probe makes close pass of Jupiter". BBC News. 27 August 2016. Retrieved 27 August 2016.
- ^ "Nasa ends year-long Mars simulation on Hawaii". BBC News. 29 August 2016. Retrieved 29 August 2016.
- ^ "Global media document historic University of Hawaiʻi Mars simulation". University of Hawaiʻi. 28 August 2016. Retrieved 29 August 2016.
- ^ "DNA sequenced in space for first time". BBC News. 30 August 2016. Retrieved 31 August 2016.
- ^ Wade, Nicholas (31 August 2016). "World's Oldest Fossils Found in Greenland". New York Times. Retrieved 31 August 2016.
- ^ "Wavy Greenland rock features 'are oldest fossils'". BBC News. 31 August 2016. Retrieved 31 August 2016.
- ^ "Antibody reduces harmful brain amyloid plaques in Alzheimer's patients". Science Daily. 31 August 2016. Retrieved 1 September 2016.
- ^ "For first time, carbon nanotube transistors outperform silicon". Phys.org. 2 September 2016. Retrieved 4 September 2016.
- ^ "Giant pandas rebound off endangered list". BBC News. 4 September 2016. Retrieved 5 September 2016.
- ^ "Four out of six great apes one step away from extinction – IUCN Red List". IUCN. 4 September 2016. Retrieved 5 September 2016.
- ^ "PHILAE FOUND!". ESA. 5 September 2016. Retrieved 5 September 2016.
- ^ Victor, Daniel (5 September 2016). "No Longer Missing: Rosetta's Philae Spacecraft Located on Comet". New York Times. Retrieved 5 September 2016.
- ^ "Asian typhoons becoming more intense, study finds". The Guardian. 5 September 2016. Retrieved 5 September 2016.
- ^ أ ب Bromwich, Jonah Engel; St. Fleur, Nicholas (14 September 2016). "Why Pluto's Moon Charon Wears a Red Cap". New York Times. Retrieved 14 September 2016.
- ^ "One-tenth of the world's wilderness lost in 2 decades". EurekAlert. 7 September 2016. Retrieved 10 September 2016.
- ^ "A tenth of the world's wilderness lost since the 1990s". EurekAlert. 8 September 2016. Retrieved 10 September 2016.
- ^ "A tenth of the world's wilderness lost since the 1990s". Science Daily. 8 September 2016. Retrieved 10 September 2016.
- ^ "DNA confirms cause of 1665 London's Great Plague". BBC News. 8 September 2016. Retrieved 9 September 2016.
- ^ "NASA's OSIRIS-REx Speeds Toward Asteroid Rendezvous". NASA. 9 September 2016. Retrieved 9 September 2016.
- ^ "Asteroid probe begins seven-year quest". BBC News. 9 September 2016. Retrieved 9 September 2016.
- ^ Corum, Jonathan (8 September 2016). "NASA Launches the Osiris-Rex Spacecraft to Asteroid Bennu". New York Times. Retrieved 9 September 2016.
- ^ Chang, Kenneth (8 September 2016). "The Osiris-Rex Spacecraft Begins Chasing an Asteroid". New York Times. Retrieved 9 September 2016.
- ^ St. Fleur, Nicholas (2016-09-08). "A Quadruple Take on the Giraffe: There are Four Species, Not One". The New York Times. Retrieved 2016-09-10.
- ^ "World's second-largest meteorite 'Gancedo' discovered in Argentina". ABC. 14 September 2016. Retrieved 15 September 2016.
- ^ "Gaia space telescope plots a billion stars". BBC News. 14 September 2016. Retrieved 14 September 2016.
- ^ "Gaia's billion-star map hints at treasures to come". ESA. 13 September 2016. Retrieved 14 September 2016.
- ^ "Nokia Bell Labs, Deutsche Telekom T-Labs and Technical University of Munich achieve speeds of 1 Tb per second in groundbreaking optical technology trial". Nokia. 16 September 2016. Retrieved 21 September 2016.
- ^ "Western Digital Demonstrates Prototype of the World's First 1 Terabyte SDXC Card at photokina 2016". Sandisk. 20 September 2016. Retrieved 21 September 2016.
- ^ "Extremotolerant tardigrade genome and improved radiotolerance of human cultured cells by tardigrade-unique protein". Nature. 20 September 2016. Retrieved 21 September 2016.
- ^ "Demystifying the resilience of water bears: Protein protects human cultured cells from radiation damage". Science Daily. 20 September 2016. Retrieved 21 September 2016.
- ^ أ ب Zimmer, Carl (21 September 2016). "How We Got Here: DNA Points to a Single Migration From Africa". New York Times. Retrieved 22 September 2016.
- ^ "East Antarctic meltwater ponds seen for first time". Science Daily. 22 September 2016. Retrieved 24 September 2016.
- ^ "Landmark Map Reveals the Genetic Wiring of Cellular Life". University of Toronto. 22 September 2016. Retrieved 25 September 2016.
- ^ "China begins operating world's largest radio telescope". PhysOrg. 25 September 2016. Retrieved 26 September 2016.
- ^ "The Incredible Shrinking Mercury is Active After All". NASA. 26 September 2016. Retrieved 27 September 2016.
- ^ "Exclusive: World's first baby born with new "3 parent" technique". New Scientist. 27 September 2016. Retrieved 27 September 2016.
- ^ "First 'three person baby' born using new method". BBC. 27 September 2016. Retrieved 27 September 2016.
- ^ "Elon Musk outlines Mars colony vision". BBC. 27 September 2016. Retrieved 28 September 2016.
- ^ "Use of body-worn cameras sees complaints against police 'virtually vanish', study finds". University of Cambridge. 29 September 2016. Retrieved 2 October 2016.
- ^ Chang, Kenneth (30 September 2016). "Rosetta Spacecraft Ends Mission With Dive Into Comet It Orbited". The New York Times. Retrieved 30 September 2016.
- ^ Chang, Kenneth (26 September 2016). "For Rosetta, a Landing and an Ending on a Comet". New York Times. Retrieved 26 September 2016.
- ^ Gannon, Megan (30 September 2016). "Goodbye, Rosetta! Spacecraft Crash-Lands on Comet in Epic Mission Finale". Space.com. Retrieved 1 October 2016.
- ^ أ ب Zimmer, Carl (5 October 2016). "What's the Longest Humans Can Live? 115 Years, New Study Says". New York Times. Retrieved 6 October 2016.
- ^ أ ب Dong, Xiao; Milholland, Brandon; Vijg, Jan (5 October 2016). "Evidence for a limit to human lifespan". doi:10.1038/nature19793. Retrieved 6 October 2016.
{{cite journal}}: Cite journal requires|journal=(help) - ^ "For women, caffeine could be ally in warding off dementia". EurekAlert. 3 October 2016. Retrieved 5 October 2016.
- ^ "The Nobel Prize in Physiology or Medicine 2016". Nobel Foundation. 3 October 2016. Retrieved 3 October 2016.
- ^ "The Nobel Prize in Physics 2016". Nobel Foundation. Retrieved 2016-10-04.
- ^ Staff (5 October 2016). "The Nobel Prize in Chemistry 2016". Nobel Foundation. Retrieved 5 October 2016.
- ^ Chang, Kenneth; Chan, Sewell (5 October 2016). "3 Makers of 'World's Smallest Machines' Awarded Nobel Prize in Chemistry". New York Times. Retrieved 5 October 2016.
- ^ "Saturn's moon Dione harbors a subsurface ocean". Science Daily. 5 October 2016. Retrieved 7 October 2016.
- ^ "Planet in star system nearest our Sun 'may have oceans'". PhysOrg. 6 October 2016. Retrieved 7 October 2016.
- ^ "Smallest. Transistor. Ever". Science Daily. 6 October 2016. Retrieved 7 October 2016.
- ^ "Immunotherapy cancer drug hailed as 'game changer'". BBC News. 9 October 2016. Retrieved 9 October 2016.
- ^ "Jemma Redmond". The Guardian. 2010-10-01. p. 41.
وصلات خارجية
 Media related to 2016 in science at Wikimedia Commons
Media related to 2016 in science at Wikimedia Commons
الكلمات الدالة:
This article may include material from Wikimedia licensed under CC BY-SA 4.0. Please comply with the license terms.